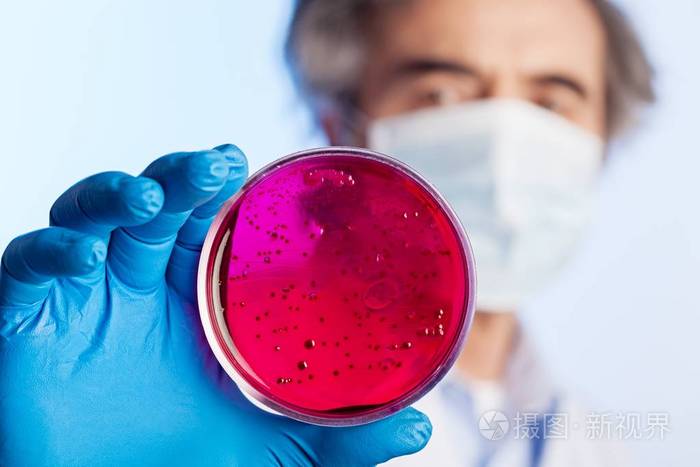
在科学家手中微生物学实验室测试照片-正版商用图片0u2y5k-摄图新视界

生物实验

试管实验 生物实验摄影图__医疗护理_现代科技_摄影图库_昵图网nipic.
图片尺寸1023x1024
中心实验室 - 华联生物科技
图片尺寸1920x1000
合阳县初中八年级学生生物实验操作技能考核圆满结束 - 美篇
图片尺寸947x1080
乌克兰境内,美军生物实验室疑似出现病毒泄露,4名工作人员感染
图片尺寸1920x1080
又到实验加试时 - 美篇
图片尺寸4032x3024
多彩生物实验 探寻生命奥秘 - 美篇
图片尺寸2000x3556
探索细胞的奥秘——2020届生物实验课 - 美篇
图片尺寸1079x1439
高一生物实验纪实(一):《高倍显微镜观察多种细胞》和《临时装片的制
图片尺寸3584x1664
高校生物实验薛雅蓉南京大学出版社9787305262593 大中专教材教辅图书
图片尺寸800x800
课程| 想知道科学dna鉴定的奥秘吗?来丽水中学生物创新实验室吧!
图片尺寸1280x960
在科学家手中微生物学实验室测试照片-正版商用图片0u2y5k-摄图新视界
图片尺寸700x467
甲第班第一节生物实验课——显微镜的使用 - 美篇
图片尺寸4032x3024
科学家在实验室里的生物技术概念照片-正版商用图片0f92k9-摄图新视界
图片尺寸700x467
生物系2020届毕业生邓大琦:"我走得比较慢,但我走得很稳"
图片尺寸3000x2000
生物科技视频素材,生物医疗视频素材下载,高清3840x2160视频素材下载,
图片尺寸3840x2160
实验
图片尺寸658x439
高一生物实验纪实(一):《高倍显微镜观察多种细胞》和《临时装片的制
图片尺寸3584x1664
海口四中2020届学生学业水平考试生物科实验操作考查纪实 - 美篇
图片尺寸800x600
高二生物组实验课精彩瞬间(一) - 美篇
图片尺寸2000x2667
防脱增发佳人神草毛囊滋养液(中科院生物研究所):抢断手的防脱生发口
图片尺寸1080x714